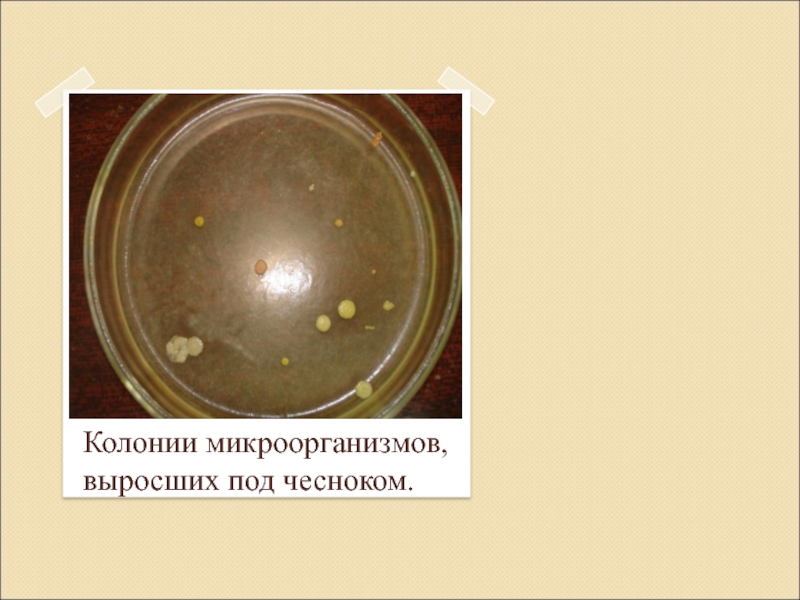
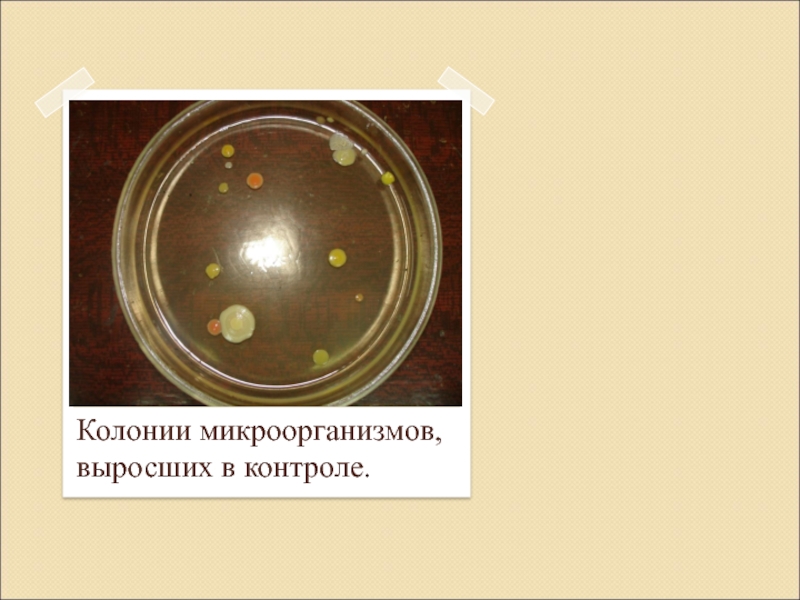

класса
МБОУ «СОШ № 11»
Руководитель: Волкова Татьяна Николаевна
- Главная
- Разное
- Образование
- Спорт
- Естествознание
- Природоведение
- Религиоведение
- Французский язык
- Черчение
- Английский язык
- Астрономия
- Алгебра
- Биология
- География
- Геометрия
- Детские презентации
- Информатика
- История
- Литература
- Математика
- Музыка
- МХК
- Немецкий язык
- ОБЖ
- Обществознание
- Окружающий мир
- Педагогика
- Русский язык
- Технология
- Физика
- Философия
- Химия
- Шаблоны, фоны, картинки для презентаций
- Экология
- Экономика
Презентация, доклад на тему Влияние фитонцидов растений на микроорганизмы
Содержание
- 1. Влияние фитонцидов растений на микроорганизмы
- 2. Актуальность исследования:экспериментальное подтверждение того, что многие растения
- 3. Задачи исследования:1. Знакомство с литературой по данному
- 4. Предмет исследования: растения с высокой фитонцидной активностьюГипотеза:систематическое
- 5. Методы исследования:НаблюдениеЭкспериментСравнениеОписаниеИзмерениеОбобщение
- 6. Токин Борис Петрович.1928 год-открытие фитонцидов.Фитонциды (от греческого слова «фитон»-растения и латинского «цедо»-убиваю)(Иванович,1983)
- 7. Сосновый и хвойный леса.
- 8. Фитонцидные растения.
- 9. Фитонцидные растения.
- 10. Фитонцидные растения.
- 11. Практическая часть.
- 12. Слайд 12
- 13. Колонии микроорганизмов,выросших под чесноком.
- 14. Колонии микроорганизмов,выросших под лимоном.
- 15. Колонии микроорганизмов,выросших под луком.
- 16. Колонии микроорганизмов,выросших в контроле.
- 17. Результаты исследования.
- 18. Выводы:1. Все изученные растения обладают антибиотическим действием
- 19. Классный час: «Фитонцидные растения для профилактики вирусных заболеваний».
- 20. Будьте здоровы!
- 21. Литература: 1. Аникеев В.В., Лукомская К.А.. Руководство
- 22. 7. Кретович В.Л. Основы биохимии растений. –
- 23. Влияние фитонцидов растений на микроорганизмы.Выполнила: Марахина Анастасия
Актуальность исследования:экспериментальное подтверждение того, что многие растения обладают фитонцидной активностью, которая губительно действует на микроорганизмы. изучение влияния фитонцидов некоторых растений на рост микроорганизмов.Цель работы:
Слайд 1Влияние фитонцидов растений на микроорганизмы.
Выполнила: Марахина Анастасия Сергеевна ученица 9 а
Слайд 2Актуальность исследования:
экспериментальное подтверждение того, что многие растения обладают фитонцидной активностью, которая
губительно действует на микроорганизмы.
изучение влияния фитонцидов некоторых растений на рост микроорганизмов.
Цель работы:
Слайд 3Задачи исследования:
1. Знакомство с литературой по данному вопросу.
2. Освоение методики выращивания
микроорганизмов из воздуха методом осаждения.
3. Выявление и сравнение фитонцидной активности различных растений.
4. Разработка рекомендаций по использованию растений с наиболее высокой фитонцидной активностью для профилактики вирусных и бактериальных заболеваний.
3. Выявление и сравнение фитонцидной активности различных растений.
4. Разработка рекомендаций по использованию растений с наиболее высокой фитонцидной активностью для профилактики вирусных и бактериальных заболеваний.
Объект исследования:
влияние фитонцидов растений на микроорганизмы рода сарцина-Sarcina .
Слайд 4Предмет исследования:
растения с высокой фитонцидной активностью
Гипотеза:
систематическое и грамотное применение растений
с высокой фитонцидной активностью является эффективным средством в борьбе с вирусными заболеваниями и как следствие способствуют укреплению иммунитета.
Слайд 6Токин Борис Петрович.
1928 год-открытие фитонцидов.
Фитонциды
(от греческого слова «фитон»-растения и латинского
«цедо»-убиваю)
(Иванович,1983)
(Иванович,1983)
Слайд 18Выводы:
1. Все изученные растения обладают антибиотическим действием на микроорганизмы.
2. Максимально это
свойство проявляется у чеснока и лимона, чуть меньше у лука.
3. Рекомендовать учащимся употреблять в пищу растения с наиболее высокими фитонцидными свойствами (чеснок, лимон, лук), с целью профилактики вирусных и бактериальных заболеваний.
3. Рекомендовать учащимся употреблять в пищу растения с наиболее высокими фитонцидными свойствами (чеснок, лимон, лук), с целью профилактики вирусных и бактериальных заболеваний.
Слайд 21Литература:
1. Аникеев В.В., Лукомская К.А.. Руководство к практическим занятиям по микробиологии.-
М.: «Просвещение», 1983. С. – 127.
2. Багрова Л.А. Детская энциклопедия «Я познаю мир». Том растения. - М.: ТКО «АСТ», 1996. - С.27 -28.
3. Введенский Б.А. Большая советская энциклопедия.- М.: «Советская энциклопедия», 1956. -С. 209-210.
4. Васильева З.П., Кириллова Г.А., Ласкина А.С. Лабораторные работы по микробиологии. – М.: «Просвещение», 1979. – С. 17-18.
5. Верзилин Н.М. По следам Робинзона. - М.: «Просвещение», 1994. - С. 136 -137.
6. Голышенков П.П. Лекарственные растения и их использование. – Саранск. Мордовское книжное издательство, 1990. - С.29-30.
2. Багрова Л.А. Детская энциклопедия «Я познаю мир». Том растения. - М.: ТКО «АСТ», 1996. - С.27 -28.
3. Введенский Б.А. Большая советская энциклопедия.- М.: «Советская энциклопедия», 1956. -С. 209-210.
4. Васильева З.П., Кириллова Г.А., Ласкина А.С. Лабораторные работы по микробиологии. – М.: «Просвещение», 1979. – С. 17-18.
5. Верзилин Н.М. По следам Робинзона. - М.: «Просвещение», 1994. - С. 136 -137.
6. Голышенков П.П. Лекарственные растения и их использование. – Саранск. Мордовское книжное издательство, 1990. - С.29-30.
Слайд 227. Кретович В.Л. Основы биохимии растений. – М.: «Советская наука», 1956.
С. 218-219.
8. Кудряшова Н.И. Лечение лимонами. - М.: «Образ – Компании», 1999. – С. 5 -7.
9.Нуралиев Ю.Лекарственные растения. – Нижний Новгород. СП «ИКПА»,1991. - С.29-31.
10. Синяков А.Ф. О вершках и корешках. - М..: «Физкультура и спорт»,1992. - С. 211 – 246.
11. Творогова А.С. Микробиологический эксперимент в школе. - Саранск, «Нива», 1987. - С. 5-10.
12. Швечикова А.П.,Косогова Т.М., Луценко А.И. Комнатные растения и чистота воздуха в помещении научно – методический журнал «Биология в школе» №1-2 1992. - С. 66 – 67.
13. «Энциклопедический словарь юного земледельца» под ред.К.А. Иванович М.: «Педагогика», 1983. - С. 329.
14. «Энциклопедический словарь юного биолога» под ред., М.С. Гилярович М.: «Педагогика», 1986. - С.37.
8. Кудряшова Н.И. Лечение лимонами. - М.: «Образ – Компании», 1999. – С. 5 -7.
9.Нуралиев Ю.Лекарственные растения. – Нижний Новгород. СП «ИКПА»,1991. - С.29-31.
10. Синяков А.Ф. О вершках и корешках. - М..: «Физкультура и спорт»,1992. - С. 211 – 246.
11. Творогова А.С. Микробиологический эксперимент в школе. - Саранск, «Нива», 1987. - С. 5-10.
12. Швечикова А.П.,Косогова Т.М., Луценко А.И. Комнатные растения и чистота воздуха в помещении научно – методический журнал «Биология в школе» №1-2 1992. - С. 66 – 67.
13. «Энциклопедический словарь юного земледельца» под ред.К.А. Иванович М.: «Педагогика», 1983. - С. 329.
14. «Энциклопедический словарь юного биолога» под ред., М.С. Гилярович М.: «Педагогика», 1986. - С.37.
Слайд 23Влияние фитонцидов растений на микроорганизмы.
Выполнила: Марахина Анастасия Сергеевна ученица 9 а
класса
МБОУ «СОШ № 11»
Руководитель: Волкова Татьяна Николаевна
МБОУ «СОШ № 11»
Руководитель: Волкова Татьяна Николаевна